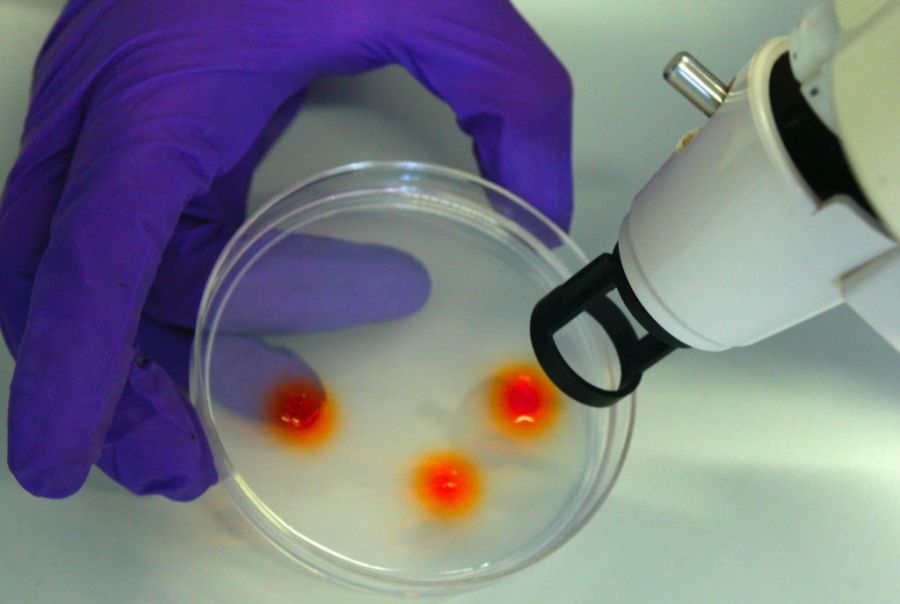
Das Spital hofft nach der Studie auf eine Zulassung der Behandlung. (Symbolbild)

Bub mit seltener Erkrankung verblüfft Ärzte nach Gentherapie
Das Hunter-Syndrom ist eine seltene Erbkrankheit. Nun wurde sie erstmals mit einer Gentherapie behandelt – mit Erfolg.

Das Wichtigste in Kürze
- Der dreijährige Oliver aus den USA wurde mit dem seltenen Hunter-Syndrom diagnostiziert.
- Er durfte an einer Studie teilnehmen, bei der er mit einer Gentherapie behandelt wurde.
- Ein Jahr nach Beginn der Therapie macht der Bub grosse Fortschritte.
Die Geschichte des kleinen Oliver berührt. Der dreijährige Bub aus den USA leidet am Hunter-Syndrom.
Dabei handelt es sich um eine Erbkrankheit, die meistens im Alter von rund zwei Jahren diagnostiziert wird. Den Betroffenen fehlt ein wichtiges Enzym zur Verarbeitung von Zuckermolekülen.
Krankheit trifft fast nur Buben
Die Krankheit kann im ganzen Körper Schaden anrichten, auch im Herz, der Leber, den Knochen und Gelenken. In den schwersten Fällen führt das Hunter-Syndrom zu geistigen Beeinträchtigungen.
Die Erbkrankheit ist extrem selten und es sind fast ausschliesslich Buben davon betroffen. In den schwersten Fällen sterben die Patienten meist, bevor sie ihr 20. Lebensjahr erreichen.
Es gibt aber Hoffnung: Am Royal Manchester Children's Hospital wurde eine Studie durchgeführt, bei der eine neue Gentherapie angewendet wurde.
Stammzellen werden im Labor verändert
Fünf Buben aus den USA, Europa und Australien nahmen teil und wurden mit der neuen Methode therapiert, wie die «BBC» berichtet.
Einer davon ist der dreijährige Oliver aus Kalifornien. Aufgrund eines defekten Gens konnte er ein Enzym, das wichtig ist, damit Zellen gesund bleiben, nicht produzieren.

In Manchester haben die Ärzte versucht, die Krankheit aufzuhalten, indem sie Olivers Zellen mittels Gentherapie verändern – mit Erfolg.
Dafür wurden ihm im Dezember 2024 Stammzellen entnommen. In einem Labor in London wurde das fehlende Gen dann in einen Virus, dessen genetisches Material entfernt wurde, eingefügt.
Eine verantwortliche Ärztin erklärt: «Wir nutzen die Maschinerie des Virus, um eine funktionierende Kopie des defekten Gens in jede der Stammzellen einzufügen.»
Behandlung schlägt an
Im Februar 2025 erhielt Oliver schliesslich die Infusion mit seinen genveränderten Stammzellen.
Heute, ein Jahr nach dem Beginn der Behandlung, scheint Oliver sich normal zu entwickeln.
Seine Mutter Jingru sagt: «Jedes Mal, wenn wir darüber reden, will ich weinen, weil es so erstaunlich ist.»
Und auch Simon Jones, Co-Leiter der Studie, meint: «Ich habe 20 Jahre darauf gewartet, einen Jungen wie Ollie zu sehen, dem es so gut geht wie ihm. Und das ist einfach unglaublich aufregend.»
Oliver «wie ein anderes Kind»
Vor der Transplantation habe der Bub überhaupt keine Enzyme produziert. «Jetzt produziert er das Hundertfache der normalen Menge», so Jones. Auf seine wöchentliche Infusion mit dem fehlenden Enzym ist er nicht mehr angewiesen.
Oliver habe auch neue Wörter und Fähigkeiten gelernt und bewege sich mit grösserer Leichtigkeit.
Der Arzt warnt jedoch: «Wir müssen vorsichtig sein und dürfen uns nicht von der Aufregung mitreissen lassen. Aber es könnte zum jetzigen Zeitpunkt kaum besser aussehen.»
Das bestätigt auch Olivers Vater Ricky: «Er ist wie ein anderes Kind. Er rennt überall herum und hört nicht auf, zu reden.»
Er zeigt sich optimistisch: «Die Zukunft für Ollie sieht sehr vielversprechend aus. Hoffentlich bedeutet das, dass mehr Kinder diese Behandlung erhalten werden.»
Spital hofft auf Zulassung
Die fünf Buben, die an der Studie teilnahmen, werden für mindestens zwei weitere Jahre beobachtet.
Spital und Universität hoffen, die Zulassung für die Behandlung zu erhalten, sollte die Studie als Erfolg gewertet werden.
Die Gentherapie muss allerdings in jungen Jahren erfolgen, da bereits existierender Schaden nicht mehr rückgängig gemacht werden kann.